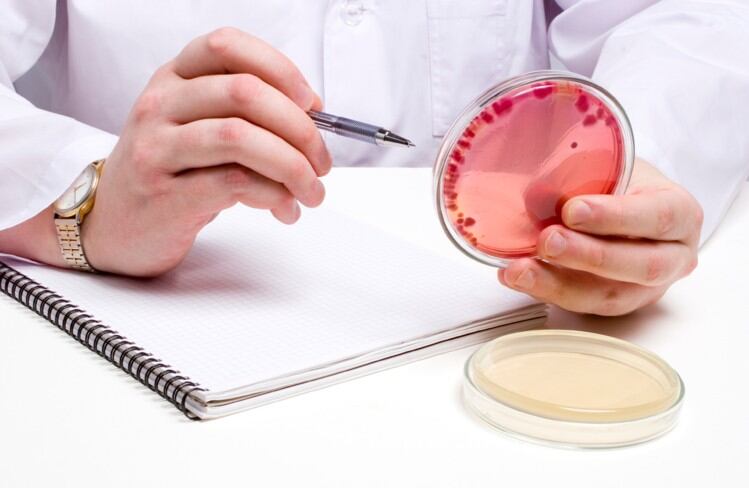

EC changes to Listeria regulation ‘will not improve food safety’
New European Commission (EC) proposals to change Listeria monocytogenes legislation threaten food safety and risk creating waste, according to the Chilled Food Association (CFA).
New European Commission (EC) proposals to change Listeria monocytogenes legislation threaten food safety and risk creating waste, according to the Chilled Food Association (CFA).

Fresh produce supplier Fresca Group boosted operating profit in a tough market over its latest financial year, despite a dip in sales.

Eating less protein, CO2 emissions labelling and gene editing were some solutions that could help reduce UK food producers’ environmental impact, according to the Department for Environment, Food and Rural Affairs’ (DEFRA’s) chief scientific advisor.